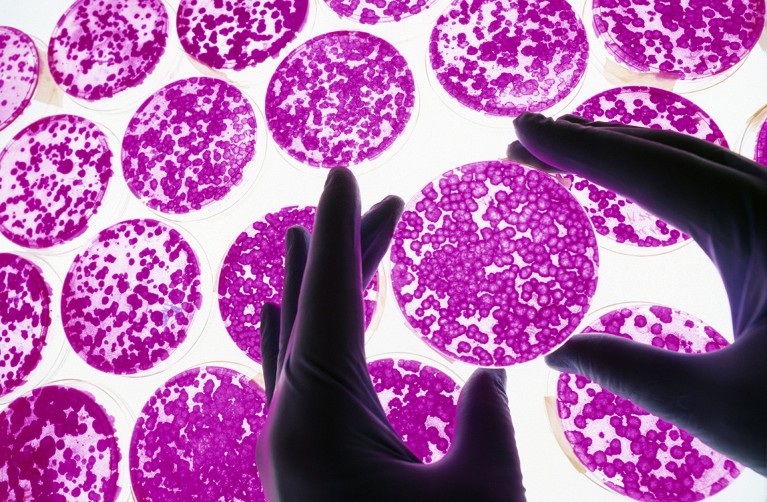
Gloved hands hold a petri dish filled with bright pink cells, surrounded by other petri dishes filled wih pink cells.

Mexico is home to the second largest medical-tourism market after Thailand.Credit: Massimo Brega/SPL
Just 20 minutes south of the Mexico–US border, in the sunny city of Tijuana, tourists from all over the world are flocking to a clinic for treatments that are mostly forbidden in their home countries.
R3 Stem Cell, a company headquartered in Scottsdale, Arizona, with Mexican clinics in Tijuana, Cancun and Puerto Vallarta, offers stem-cell therapies for conditions ranging from diabetes and lung disorders to autism and cerebral palsy. Although small, early-phase studies hint that stem cells could become a promising treatment pathway for these conditions, there are no large, rigorous trials showing that they are safe and effective, says Andrés Gómez de León, a haematologist at the Autonomous University of Nuevo León in Monterrey, Mexico.
R3 Stem Cell’s founder David Greene says that there are hundreds of peer-reviewed studies on the benefits of stem cells for many conditions, but adds that “there will always be arguments against new technology such as stem-cell therapy, especially from biased competitors and academics who dislike commercial endeavours”. So far, no adverse events have occurred at R3 Stem Cell’s facilities, which adhere to the safety and quality-control standards of the US Food and Drug Administration (FDA), he adds.
In Mexico, the company’s treatments cost anything from US$3,750 to $44,500, according to its website — roughly one-third as much as equivalent treatments in the United States (where available). Although these therapies are not approved by the FDA, there is great demand for them in Mexico, says Samantha Brechner, president of R3 Stem Cell. “We have doubled the number of patients that we’re seeing this year from two years ago,” she says.

A pipette being used to manipulate embryonic stem cells.Credit: TEK Image/SPL
Such treatments are also not officially approved by the Federal Commission for Protection Against Sanitary Risks (COFEPRIS), Mexico’s equivalent of the FDA. However, the country lacks specific laws that regulate advanced cell-based therapies as drugs or procedures.
Although official figures on the scale of the industry are scarce, R3 Stem Cell’s Tijuana clinic is one of dozens scattered across Mexico that offer stem-cell therapies to medical tourists, many of whom are from countries where such therapies are restricted. Some researchers worry that the proliferation of these unproven therapies could hinder rigorous efforts to develop stem-cell treatments. Others are pushing Mexico’s government to enforce tougher regulations to stymie the market. “We need to tackle this problem,” says Lilia Carolina Leon-Moreno, a biomedical scientist at pharmaceutical company Sophia in Guadalajara, Mexico. She adds that the growth of unproven stem-cell treatments could erode public trust in science and medicine, particularly when such procedures either provide no real benefit or can even cause harm. “In short, unproven therapies fail patients and slow down the entire field,” says Leon-Moreno.
Hope and hype
Since stem cells were first discovered more than half a century ago, a flurry of research has sought to harness their ability to become virtually any kind of cell, the aim being to create therapies that replace and rebuild damaged tissue. These studies have led to only a handful of FDA-approved therapies, which use haematopoietic stem cells — found in the bone marrow and blood — to treat certain blood disorders and cancers, such as sickle-cell disease and leukaemia. The FDA stipulates that these treatments, which are also called bone-marrow transplants, should be used only to treat blood disorders because of a lack of evidence that they are safe and effective for other conditions. Similarly, COFEPRIS has approved haematopoietic stem-cell transplants for blood disorders and cancers, but not stem-cell therapies that are still undergoing trials.
The future of stem-cell research seems bright, with efforts under way to get more treatments onto the FDA’s approved list. Globally, there are more than 2,000 stem-cell-related trials listed on the US National Institutes of Health’s clinical-trial register. More than half of these are phase II studies, which focus on investigating how effective potential therapeutics are. Another 291 are phase III trials, the final stage before regulatory approval, and 74 are to assess treatments already on the market. Beyond blood disorders, stem cells are showing particular promise in treating Parkinson’s disease and spinal-cord injury, says Jaime Imitola, a clinician-scientist specializing in neurology at the University of Connecticut in Farmington. “There is a lot of hope,” he says.
How a mathematician is cracking open Mexico’s powerful drug cartels
But that doesn’t mean that the treatments are close to being suitable for patients, he adds. It could be around two decades before most of these stem-cell therapies become part of mainstream medicine, says Alejandro Garcia Ruiz, a molecular biologist at Dartmouth College in Hanover, New Hampshire. This is because researchers still don’t understand the mechanisms behind the regenerative powers of these cells and the complex process by which they transform into different cell types, he says. “We haven’t really finished understanding how they work,” he says.
Still, the glimmers of hope and the often breathless excitement among stem-cell researchers over the years has fuelled hype about the cells’ therapeutic potential, says Timothy Caulfield, a health-law and science-policy researcher at the University of Alberta in Edmonton, Canada. Many clinics list stem-cell studies and reviews, whatever their relevance, on their websites to seem legitimate to people who are struggling to find effective treatments for chronic conditions, says Caulfield.
Medical-tourism hotspot
Mexico is home to the world’s largest medical-tourism market after Thailand, and attracts more than one million foreigners seeking treatment every year. But it’s unclear how many of these medical tourists receive unproven stem-cell treatments. This isn’t unique to Mexico: clinics that market stem-cell treatments also crop up in the United States, China, India and elsewhere. But several factors have created particularly fertile ground in Mexico, says Caulfield.
One is the lack of regulation of stem-cell therapies. “There’s no law that explicitly prohibits stem-cell treatments,” says Leon-Moreno. Although the country’s general health law requires COFEPRIS to regulate the use of organs, tissues and cells and prohibits their sale, it doesn’t explicitly mention stem-cell treatments. This has created a loophole that allows clinics and therapies to flourish unchecked, says Leon-Moreno, who is a member of the International Society for Cell and Gene Therapy’s legal and regulatory affairs committee. Nature asked COFEPRIS about how stem cells are regulated in the country, but did not receive a response.
On 15 January, the Mexican government published a series of reforms to the general health law, including one that prohibits the donation of blood products and stem cells for commercial or profit-making purposes. Although a step in the right direction, the updated law is still ambiguous and covers only standard haematopoietic stem cells, says Leon-Moreno.
Under pressure: the reality of Mexico’s research system
It is also relatively easy for businesses to obtain a ‘sanitary licence’ from COFEPRIS that allows health establishments to source, handle and use organs, tissues and cells, says Garcia Ruiz. It costs around $900 and is valid for five years, he adds. Many stem-cell clinics use this credential to make them look “COFEPRIS-approved”, says Leigh Turner, a bioethicist at the University of California, Irvine, who has investigated stem-cell tourism. Establishing a stem-cell-therapy clinic also doesn’t require expensive, advanced equipment or specialized staff to administer treatments, says Turner. In most cases, the main items needed are intravenous kits, which include catheters, bags and tubing. “We’re not talking about millions of dollars or really sophisticated equipment,” he says. “Mostly you need a budget for marketing.”
Although official data are scarce, many stem-cell clinics in Mexico seem to be owned by US companies looking to take advantage of the country’s relatively relaxed regulatory environment. In the United States, the FDA considers stem cells to be drugs if they have been altered, cultured in the laboratory, combined with compounds or applied to tissues that differ from the ones they come from. That means that the stem cells would need to undergo clinical trials and approval before being marketed as treatments.
Some stem-cell clinics have become magnets for celebrities, including top athletes and social-media influencers. In August 2025, US-based socialite Kim Kardashian travelled to a Mexican stem-cell clinic to be treated for chronic back pain. “It creates this impression that these therapies are ready for prime time,” says Caulfield.
Unregulated risk
The demand for these unproven treatments in Mexico is also fuelling the growth of local tissue banks that source, store and manufacture stem cells, with some doubling as clinics, says Leon-Moreno. In Guadalajara alone, Leon-Moreno estimates that there are a dozen such facilities, which supply clinics around the country. Most tissue banks collect stem cells from umbilical cords or placentas after caesarean sections. A major problem is that many of these banks aren’t certified by COFEPRIS and there is no standard protocol for managing and handling stem cells, leading to inconsistent products, says Leon-Moreno. “Maybe people aren’t getting stem cells at all,” adds Turner.
Given the scale of the industry, complications related to stem-cell treatments seem to be relatively rare, says Paul Knoepfler, a biologist at the University of California, Davis who tracks stem-cell treatments and clinics globally. But adverse effects are likely to be under-reported because most stem-cell clinics are private and therefore don’t openly share this information, he adds. People who experience complications are also often hesitant to speak out because of privacy concerns, embarrassment and not wanting to get physicians into trouble. “The amount of data on adverse events is still so low, so it’s hard to know for sure what’s going on,” says Knoepfler.

A researcher uses a microscope to study cultured stem cells.Credit: GARO/PHANIE/SPL
One of the most common risks is that of picking up an infection caused by contaminated material and poor handling, adds Knoepfler. A May 2024 report1 from the US Centers for Disease Control and Prevention detailed three people who were infected with Mycobacterium abscessus, which is difficult to treat, after receiving embryonic-stem-cell injections in separate locations in Mexico. The use of stem cells derived from birth tissue, such as the umbilical cord and placenta, is inherently risky because these tissues naturally contain bacteria that can wreak havoc in treatments, adds Knoepfler. And effectively sterilizing stem cells sourced in this way often requires irradiation, which can severely damage them and wipe out their ability to develop into different cells.



